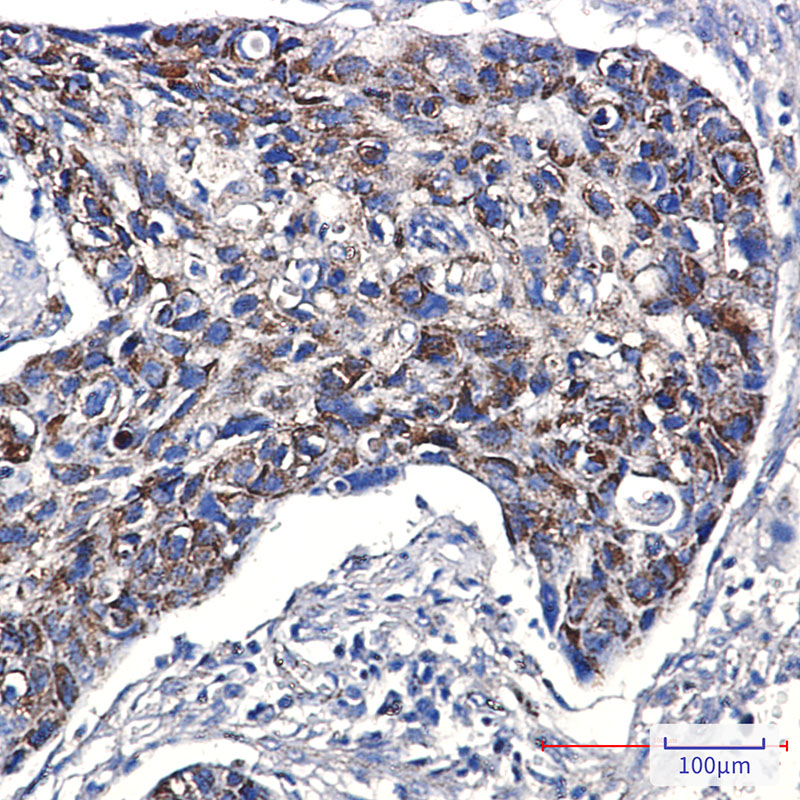

您当前的位置:
Conjugation/Formulation:Un-conjugated
- Background The balance between fission and fusion regulates the morphology of mitochondria. TTC11 is a component of a mitochondrial complex that promotes mitochondrial fission (James et al., 2003 [PubMed 12783892]).[supplied by OMIM, Mar 2008]
- Immunogen A synthetic peptide of human TTC11
-
Gene ID
51024
-
Swiss Prot
Q9Y3D6
- Synonyms TTC11; CGI-135;FIS1
- Reactivity Human
- Application WB, IHC-P
-
Recommended dilution
WB: 1:1000-1:5000
IHC-P: 1:1000-1:5000 - Calculated MW 17 kDa
- Observed MW 17 kDa
- Host species Rabbit
- Clonality Monoclonal
- Clonality No. DGR15592
- Isotype IgG
- Purity Affinity Purification
- Conjugation Un-conjugated
- Storage/Stability Store at -20°C. Supplied in 50mM Tris-Glycine(pH 7.4), 0.15M NaCl, 40% Glycerol, 0.01% sodium azide and 0.05% BSA. Stable for 12 months from date of receipt.
-
 Western blot detection of TTC11/FIS1 in Jurkat,Hela cell lysates using TTC11/FIS1 antibody(1:1000 diluted).
Western blot detection of TTC11/FIS1 in Jurkat,Hela cell lysates using TTC11/FIS1 antibody(1:1000 diluted). -
Immunohistochemical analysis of paraffin-embedded human lung cancer using db14626 antibody.
Immunohistochemical analysis of paraffin-embedded human lung cancer using db14626 antibody.
订购信息
- Package Price (RMB)
- 10μL 398
- 20μL 698
- 50μL 1398
- 100μL 2398
- 货期:现货
相关产品
For research use only. Not intended for diagnostic.
